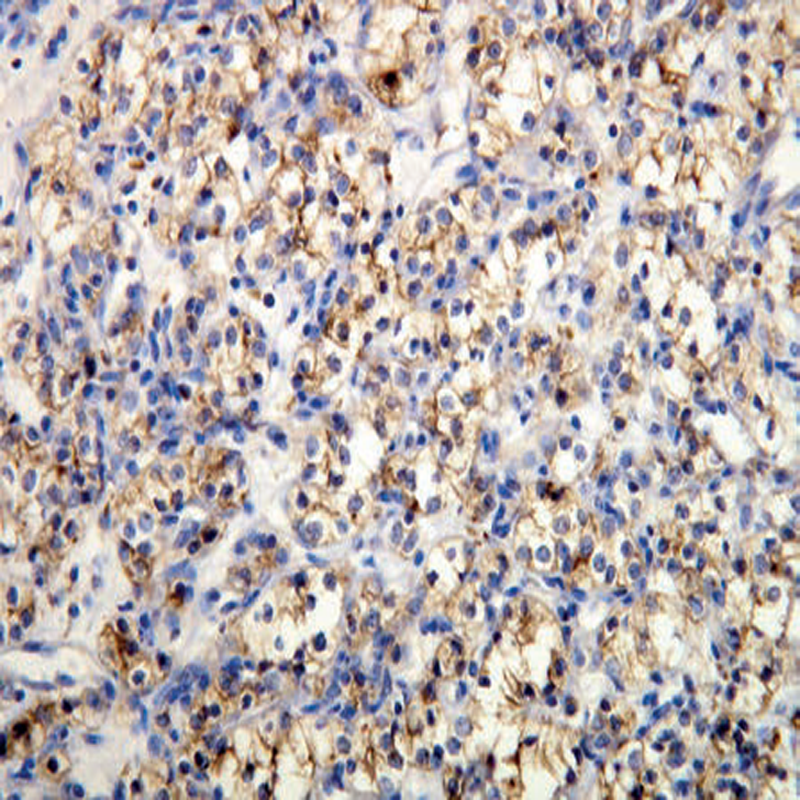

IHC Products
- Anti-ER (Estrogen Receptor)
- Anti-PR (Progesterone Receptor)
- Anti-C-erbB-2 (Her-2/neu)
- Anti-CD10
- Anti-CD20
- Anti-CD117
- Anti-C4d complement
- Anti-EMA
- Anti-Ki-67
- Anti-Cytokeratin 7
- Detection KIT - rabbit/mouse dual, HRP/DAB
- Primary Antibody diluent
© 2020 GSM Diagnostic Co.,Ltd. All rights reserved | Powered by Myanmar Web Designer